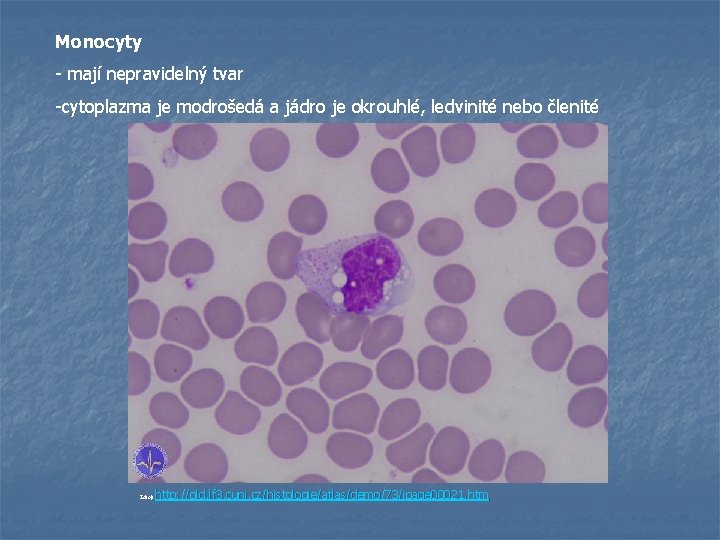

Tkn I Epitely a pojiva Mgr Libue VODOV

Tkáně I. Epitely a pojiva Mgr. Libuše VODOVÁ Katedra biologie Pd F MU Zdroj: http: //strucneocloveku. blog. cz/

Tkáně Epitely Podle tvaru dlaždicový kubický cylindrický Pojiva vyplňovací a oporná vazivo chrupavka kost Podle vrstev Pojiva trofická krev jednovrstevný mnohovrstevný míza tkáňový mok Podle funkce Výstelkový a krycí Rezorpční Řasinkový Smyslový Svalový Žlazový Respirační Pigmentový Svalová Nervová

Tkáně = soubory buněk, které mají stejný tvar a vykonávají stejnou funkci Typy tkání: § § Tkáň epitelová (Epitel) Tkáň pojivová (Pojivo) Tkáň svalová Tkáň nervová

I. EPITELY = tkáně, které tvoří u sebe těsně ležící buňky, jsou bez mezibuněčné hmoty - kryjí povrchy a vystýlají dutiny - většinou plní více funkcí, ale jsou upraveny k výkonu jedné specifické funkce (ochranná, vyměšovací, smyslová apod. ) Apikální (distální) pól epitelová buňka Jádro Bazální (proximální) pól Bazální membrána Jak poznáme epitelovou buňku? buňky leží těsně u sebe buňky polarizovány – každý pól má odlišnou morfologii

TYPY EPITELŮ A) Podle tvaru a výšky buněk: 1) dlaždicový (plochý; obr. A) 2) kubický (krychlový; obr. B) 3) cylindrický (válcovitý; obr. C) D - víceřadý cylindrický (viz další členění) s řasinkami (1) a pohárkovými buňkami (2) Zdroj: http: //www. med. muni. cz/histol/Med. Atlas_2/HP_txt 42 -2. htm

TYPY EPITELŮ B) Podle počtu vrstev buněk v epitelu 1) Jednovrstevný epitel – z 1 vrstvy buněk Jednovrstevný plochý epitel (obr. A) - vystýlá krevní a lymfatické cévy - poplicnice, pohrudnice Jednovrstevný kubický epitel (obr. B) - pigmentová vrstva sítnice komorového oka Jednovrstevný cylindrický epitel (obr. C) - vystýlá trávicí soustavu obratlovců - vystýlá vejcovody Zdroj: http: //www. med. muni. cz/histol/Med. Atlas_2/HP_t xt 4 -2 -2. htm

Víceřadý epitel - z nestejně vysokých buněk - všechny buňky nasedají na bazální membránu, ale ne všechny dosahují k povrchu - u stejně vysokých buněk jsou jádra v jedné rovině, buněk nad sebou Př. Sliznice vystýlající dýchací cesty savců (na obrázku výstelka průdušnice) Zdroj: http: //old. lf 3. cuni. cz/histologie/atlas/demo/24/ipage 00005. htm

2) Mnohovrstvý (vrstevnatý) epitel – z několik vrstev buněk ležících nad sebou - na bazální membránu nasedá spodní vrstva - podstatný je tvar nejsvrchnější vrstvy buněk vrstevnatý epitel plochý (dlaždicový) - b. se směrem k povrchu zplošťují - tam, kde dochází k oděru - dutina ústní, hltan, jícen, pochva, řiť - obr. A – nerohovatějící - obr. B - rohovatějící vrstevnatý epitel kubický vrstevnatý epitel cylindrický (obr. C) - oba jsou v organismech vzácné Mnovrstevné epitely A - dlaždicový nerohovatějící B - dlaždicový rohovatějící C – cylindrický D – přechodný Zdroj: http: //www. med. muni. cz/histol/Med. Atlas_2/ HP_txt 4 -2 -2. htm

přechodný (přechodní epitel (obr. D) – největší buňky jsou na povrchu (někdy se 2 jádry) a kryjí více menších buněk ležících pod nimi – viz obr. - je uzpůsoben k roztahování a stahování orgánu př. Výstelka močových cest savců smrštěný: maximálně zploštělý - 4 -5 vrstev; naplněný: 2 -3 vrstvy Přechodný epitel u naplněného močového měchýře Zdroj: http: //katalog. lf 3. cuni. cz/katalog/items/278 -export. jpg

TYPY EPITELŮ B) Podle funkce: 1) Výstelkový a krycí 2) Rezorpční 3) Řasinkový 4) Smyslový 5) Svalový 6) Žlazový 7) Respirační 8) Pigmentový

TYPY EPITELŮ B) Podle funkce: 1) Epitely výstelkové a krycí – hl. funkce: ochranná – na povrchu těla ( pokožka), uvnitř – vystýlají dutiny - další funkce: zábrana před vysýcháním, přijímaní podnětů z prostředí (smyslové b. ), resorpce, dýchání, termoregulace, chemická ochrana Př. Epidermis – jednovrstevná (bezobratlí) - vícevrstevná (obratlovci) -rohovatějící vrstevnatý dlaždicový epitel nerohovatějící dlaždicový epitel – dutina ústní, jícen, vagína endotel vystýlající cévy savců přechodní epitel močových cest

Zdroj: http: //www. zoologie. upol. cz/atlas_histologie/tkane-epitelove--funkcni-klasifikace-epitelu. pdf

2) Rezorpční – funkce: ke vstřebávání (resorpci) živin - na povrchu buněk jsou mikroklky (větší povrch=>větší resorpční plocha) – „žíhaný lem“ Př. cylindrický epitel tenkého střeva, kubický epitel nefronu ledvin Jednovrstevný cylindrický resorpční v tenkém střevě člověka Zdroj: http: //www. zoologie. upol. cz/atlas_histologie/tkane-epitelove--funkcni-klasifikace-epitelu. pdf

Jednovrstevný cylindrický resorpční v tenkém střevě člověka Zdroj: http: //www. sci. muni. cz/ptacek/HISTOLOGIE 2. htm#resorbcni

řez tenkým střevem člověka - na povrchu epitelu viditelný žíhaný lem Zdroj: http: //www. profimedia. . cz/fotografie/ cross--casti. Zdroj: http: //www. profimedia cz/fotografie/cross casti-lidskehotenkehoprofimedia-0039676234. jpg tenkeho-streva-ukazujici-povrch/profimedia

3) Řasinkové - na povrchu mají řasinky – funkce: 1. pohyb (těla – ploštěnky, sekretu, oocytů, spermií apod. ) 2. přijímání potravy (výstelka střevní dutiny láčkovců) Př. víceřadý řasinkový epitel - vystýlající dýchací cesty savců (žlázové b. produkují sekret, zachycující cizí částice a řasinky jej posunují ven) - vystýlající vejcovody a chámovody obratlovců

Víceřadý cylindrický epitel vystýlající průdušky Zdroj: http: //old. lf 3. cuni. cz/histologie/atlas/demo/25/ipage 00002. htm

4) Smyslové – funkce: přijímání smyslových podnětů - epitelové b. (podpůrná fce) + smyslové b. Př. Chuťové pohárky (2) - soudečkovité útvary uložené v epitelové vrstvě v okolí jazykových papil Zdroj: http: //old. lf 3. cuni. cz/histologie/atlas/demo/7/ipage 00005. htm

Čichová sliznice 1 - Čichový epitel 2 - Lamina propria 3 - Bowmanova čichová žláza 4 - Krevní céva 5 - Basální buňky 6 - Jádra podpůrných buněk Zdroj: http: // old. lf 3. cuni. . cz/histologie/Atlas 0/ labels. . php? fotka=284 Zdroj: http: //old cz/histologie/Atlas 0/labels php? fotka=284

5) Svalové – funkce: stažitelnost - buňky mají rozšířenou bázi s kontraktilními fibrilami – lze je stahovat Př. U nižších obratlovců (láčkovců ve výstelce střevní dutiny)

6) Žlázové – funkce: sekrece - Obsahují specializované buňky (žlázy), které produkují sekret Př. Pohárkové buňky v epitelu dýchacích cest Mazová žláza u vlasového váčku v kůži víčka člověka. http: //www. sci. muni. cz/ptacek/HISTOLOGIE 2. htm#zlazy

7) Respirační – funkce: výměna plynů - Př. Velmi tenká výstelka plicních sklípků 8) Pigmentové -fce: k absorpci světla -Př. V sítnici komorového oka

II. POJIVA = tkáně, které jsou tvořeny buňkami a mezibuněčnou hmotou, kterou tyto buňky produkují (odděluje buňky) Funkce pojiv: § Vyplňují prostory mezi orgány § Opora těla § Obalují orgány § Trofická a exkreční fce (předávání produktů metabolismu) § Ukládání rezervních látek § Nositelé imunity (produkce protilátek)

Pojivová tkáň se skládá z buněk a mezibuněčné hmoty Zdroj: http: //strucneocloveku. blog. cz/

n Typy pojiv A) Pojiva vyplňovací a oporná (vazivo, chrupavka, kost) B) Pojiva trofická (krev, míza, tkáňový mok)

A) Pojiva vyplňovací a oporná (vazivo, chrupavka, kost) Ø 1. Vazivo A) Mezibuněčná hmota - polotekutá rosolovitá amorfní („beztvará“) složka = základní hmota - vláknitá složka: kolagenní vlákna – pevná a ohebná elastická – pružná, ale méně pevná retikulární - tuhá B) Buňky: - fixní (pevné) - se stálou polohou Př. fibroblasty – produkují vláknitou a amorfní složku pigmentové buňky tukové buňky - bloudivé (volné) -mohou cestovat makrofágové – schopnost fagocytovat velké částice (IMUNITA) žírné buňky – produkující heparin (brání srážení krve) a histamin (zvyšuje propustnost cév)

Ø 2. Chrupavka - pevná a pružná tkáň (oporné pojivo) - Mezibuněčná hmota + buňky (chondrocyty) - mezibuněčná hmota silně vyvinuta (pevnost v tahu) - u obratlovců - zárodečný skelet (postupná náhrada kostí) - do dospělosti (štítná, ušní boltce atd. ) Chondrocyty obklopené mezibuněčnou hmotou Zdroj: http: //old. lf 3. cuni. cz/histologie/atlas/demo/25/ipage 00003. htm

3 typy: a) hyalinní (sklovitá) - nejčastější typ - průsvitá, bílá až namodrale poloprůsvitná - chondrocyty uloženy v mezibuněčné hmotě - základ většiny kostí př. zárodečný skelet, chrupavka štítná, konce žeber, kloubní chrupavky, chrupavky průdušnice a průdušek Chondrocyty uspořádané do skupin u hyalinní chrupavky Zdroj: http: //www. cytochemistry. net/microanatomy/bone/cartilage_and_bone_cells. htm

- elastická - v mezibuněčné hmotě kolagenní i elastická vlákna, - žlutobílá - velmi pružná - chondrocyty netvoří skupiny - př. ušní boltec, Eustachova trubice Elastická chrupavka Zdroj: http: //www. sci. muni. cz/ptacek/HISTOLOGIE 2_soubory/image 172. jpg

- vazivová (vláknitá) – obsahuje velké množství silných svazků kolagenních vláken => odolnost v tahu a tlaku – matně bílá (na řezu neprůhledná) - mezibratlové ploténky, nitrokloubní destičky, součást křížokyčelního kloubu a symfýzy Zdroj: http: //www. meddean. luc. edu/lumen/Med. Ed/Histo/frames/h_fra me 9. html

Ø - 3. Kost žlutobílá nejtvrdší pojivová tkáň - Pouze u obratlovců (šupiny ryb, kožní desky krokodýlů a želv) podpůrná a ochranná funkce Tvoří ji: 1) buňky : osteoblasty –produkují základní hmotu osteocyty – kostní hmotu již neprodukují, uvolňují minerální látky ze základní hmoty (regulují mn. Ca v tělních tekutinách) osteoklasty – odbourávají kostní hmotu 2) mezibuněčná hmota – z organických látek, anorg. l. a vody Organické l. – svazky kolagenních vláken (ossein) - Anorganické l. – mikrokrystaly Ca 3 (PO 4)2 a Ca CO 3 - poměr organických a anorganických látek se s věkem mění novorozenec 52% organických l. , 48% anorganických l. – kosti měkčí, ale pružné dospělý člověk 40% organických l. , 60 % anorganických l. – kosti tvrdé, ale křehčí

Stavba kosti: 1) Okostice (periost, periosteum) – vazivová blána (tuhé kolagenní vazivo) na povrchu - bohatě prokrvená, nervová zakončení (poranění bolestivá ) Zdroj: http: //drugster. info/img/ail/553_556_2. jpg Zdroj: http: //www. kiesbeter. nl/object_binary/o 2289. gif

2) vlastní kostní tkáň A) vláknitá (fibrilární) – nepravidelně uspořádaná (propletené svazky kolagenních vláken s osteocyty) např. švy na lebce, drsnatiny na kostech B) vrstevnatá (lamelární) – skládá se vrstviček (lamel) -hutná, kompaktní kost – s válcovitými osteony (v jejich středu Haversův k. ) - silná povrchová vrstva kostí (diafýzy dlouhých kostí) - houbovitá, spongiózní – bez Haversova systému - ze silných kostních trámců - střední č. krátkých kostí, lebečních kostí a epifýz dlouhých kostí

Vnitřní stavba kosti Haversův kanálek Kostní trámce Kostní dřeň Spongiózní k. Kompaktní k. Okostice Zdroj: http: //www. jameda. de/gesundheits-lexikon/bilder/524715. jpg

Stavba kosti kompaktní Haversův kanál obsahující cévy a nervy Výstelka kostní Okostice dutiny Haversův kanál Krevní cévy Příčný kanál Kanálek Oseteocyt Zdroj: http: //blog. dearbornschools. org/renkom/files/2011/02/Bone. Compact-and-spongy. gif

3) kostní dřeň vyplňuje dutiny dlouhých a plochých kostí tvořena retikulárním vazivem obsahuje tukové buňky a mateřské buňky krvinek Probíhá v ní krvetvorba (v dospělosti pouze v krátkých a v některých plochých kostech –červená kostní dřeň) Dřeň dlouhých kostí podléhá degeneraci – mění se na dřeň žlutou (tuková)

B) Pojiva trofická (krev, míza, tkáňový mok) - Tvořeny tekutou složkou a krevními buňkami U všech živočichů kromě hub U bezobratlých: lymfa a hemolymfa, krev (uzavřený CS) U obratlovců: krev, lymfa, tkáňový mok Funkce: v Výměna látek a metabolitů ve tkáních v Výměna plynů ve tkáních v Rozvod produktů žláz s vnitřní sekrecí v Nositelé imunity organismu

1. Krev A) Krevní plazma - nažloutlá tekutina - 90% vody, plyny (kyslík, dusík, oxid uhličitý), bílkoviny (fibrinogen a protrombin – srážení krve a další), minerální soli, glukóza, rozváděné hormony a odpadní zplodiny metabolismu (močovina) Zdroj: http: //img 2. ct 24. cz/multimedia/images/4/361/middle/36004. jpg

B) Krevní buňky: -1. červené krvinky (erytrocyty) – u savců bezjaderné => bikonkávní (dvojduté) - pružné - snadno přizpůsobí svůj tvar – průchod kapilárami - neustále se obnovují - životnost: u člověka 90 -120 dní (u ptáků 20 -40 d, u žab 700 -1200 d) - v 1 mm 3 krve: 5 mil. erytrocytů (muž) 4, 5 mil erytrocytů (žena) Fce: přenášení plynů – dýchací barvivo hemoglobin (u obratlovců), u bezobratlých jiná dýchací barviva http: //legacy. owensboro. kctcs. edu/GCaplan/anat 2/notes/Imag e 329. gif http: //jsgreen jpg http: //jsgreen. . tamu. edu/Blood%20 erythrocytes%20 for%20 therapy%20 page. jpg

- 2. bílé krvinky (leukocyty) 10 000 - kulovité a jaderné - v 1 mm 3 krve výrazně menší množství než erytrocytů: 5 - Typy: a) Granulocyty - typologie dle barvitelnosti na: neutrofilní – 60 -70% leukocytů eozinofilní - 2 - 4% leukocytů bazofilní – 1% leukocytů Erytrocyt, trombocyt a leukocyt http: //sestra. org/images/thumb/9/96/Krev. jpg/400 px-Krev. jpg

Neutrofilní granulocyty - 60 -70% leukocytů - mají jádro rozčleněno na 2 -5 segmentů (podle stáří: u nezralých b. je podkovovité (podle stáří: nesegmentované; u zralých b. jsou laloky spojeny můstky z chromatinu – viz obr. ) - fagocytují malé částice – mikrofágové -schopnost prostupovat stěnou vlásečnic do tkání Zdroj: http: //old. lf 3. cuni. cz/histologie/atlas/demo/73/ipage 00001. htm

Eozinofilní granulocyty - 2 - 4% - množí se při alergiích a parazitálních onemocněních - jádro je složeno ze dvou laloků - cytoplazma je růžovofialová s velkými zrnky Zdroj: http: //old. lf 3. cuni. cz/histologie/atlas/demo/73/ipage 00009. htm

Bazofilní granulocyty - 1% leukocytů - jádro je obvykle překryto zrnky (granuly) tmavě modré až černé barvy, která obsahují heparin Zdroj: http: //old. lf 3. cuni. cz/histologie/atlas/demo/73/ipage 00013. htm

b) Agranulocyty – v plazmě nemají zrnka (granula) lymfocyty – účastní se imunitní reakce organizmu; 20% T-lymfocyty – prošly brzlíkem (Thymus) - buněčná imunita – obrana proti nádorům, virům, transplantační reakce B-lymfocyty - látková imunita – podílejí se na tvorbě protilátek Lymfocyt monocyty – největší krvinky (u člověka 15 -20 μm); 5% - schopnost amébovitého pohybu (prostupují tkáněmi) a fagocytózy velkých částic - makrofágové http: //media. rozhlas. cz/_obrazek/01001527. j peg? im=1&mand=gt&sc_x=1024&sc_y=768

Lymfocyty - poznáme podle velkého kulovitého jádra se zářezem Zdroj: http: //old. lf 3. cuni. cz/histologie/atlas/demo/73/ipage 00014. htm
Monocyty - mají nepravidelný tvar -cytoplazma je modrošedá a jádro je okrouhlé, ledvinité nebo členité http: //old. lf 3. cuni. cz/histologie/atlas/demo/73/ipage 00021. htm Zdroj:

- 3. krevní destičky (trombocyty) - nejsou to buňky, ale tělíska, která vznikají odškrcováním od výběžků velkých b. v kostní dřeni (megakaryocyty) - v 1 mm 3 krve je 300 000 tromobocytů - tvoří se v kostní dřeni, slezině, brzlíku a lymfatických uzlinách - princip fungování: porušení endotelu cév – rozpad tromobocytů; účinkem enzymu trombokinázy se za přítomnosti Ca 2+ mění protrombin na trombin, který aktivuje přeměnu fibrinogenu v plazmě na fibrin; fibrinová vlákna vytvoří síť, která uzavře otevřené krevní řečiště (krevní koláč); fibrinová síť se smršťuje, vytlačuje se krevní sérum http: //www. ortopedie-ostrava. cz/

2. Míza (Lymfa) - bezbarvá nebo bělavá (míza s obsahem tuků) - složením podobná krevní plazmě: stejný obsah solí, menší množství bílkovin - obsahuje krevní buňky: lymfocyty a ojediněle také eozinofilní leukocyty a monocyty - vzniká z tekutin, které vyloučí stěna krevních kapilár a buňky tkání (= z tkáňového moku)

3. Tkáňový mok - vzniká prostupováním tekutiny z krve přes stěny kapilár do mezibuněčných prostor - podobné složení jako krevní plazma: méně bílkovin Funkce: látková výměna mezi kapilárami a buňkami

n Děkuji za pozornost.
- Slides: 50